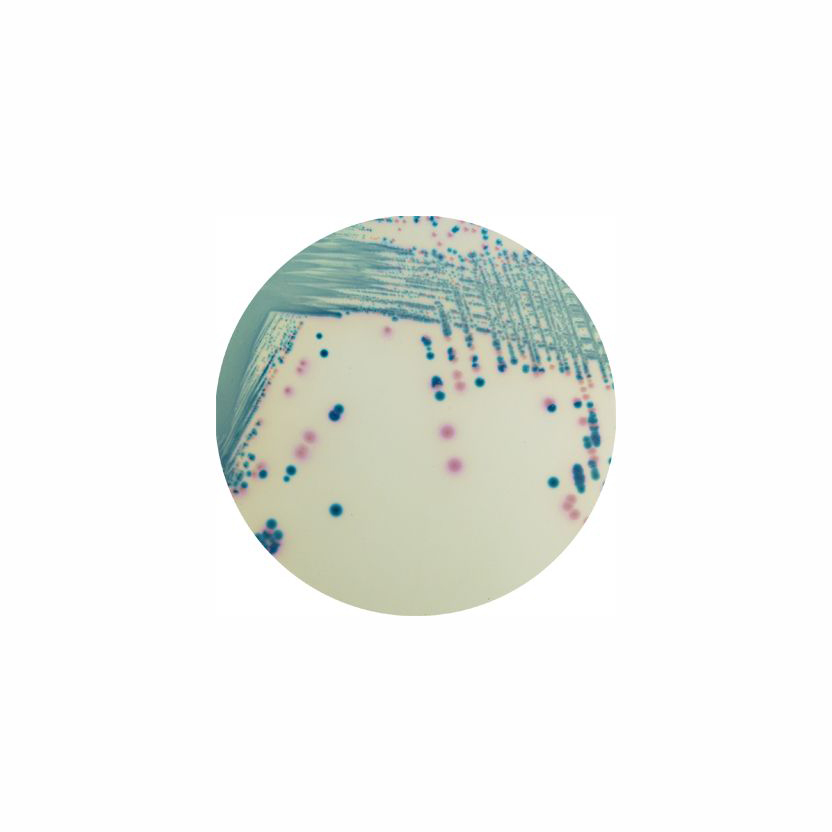

Über das Produkt
Chromogenes Medium zur Detektion und Isolierung von Carbapenemase-produzierenden Enterobacterales (CPE).
CHROMagar mSuperCARBA (5L)
Chromogenes Medium zur Detektion und Isolierung von Carbapenemase-produzierenden Enterobacterales (CPE).